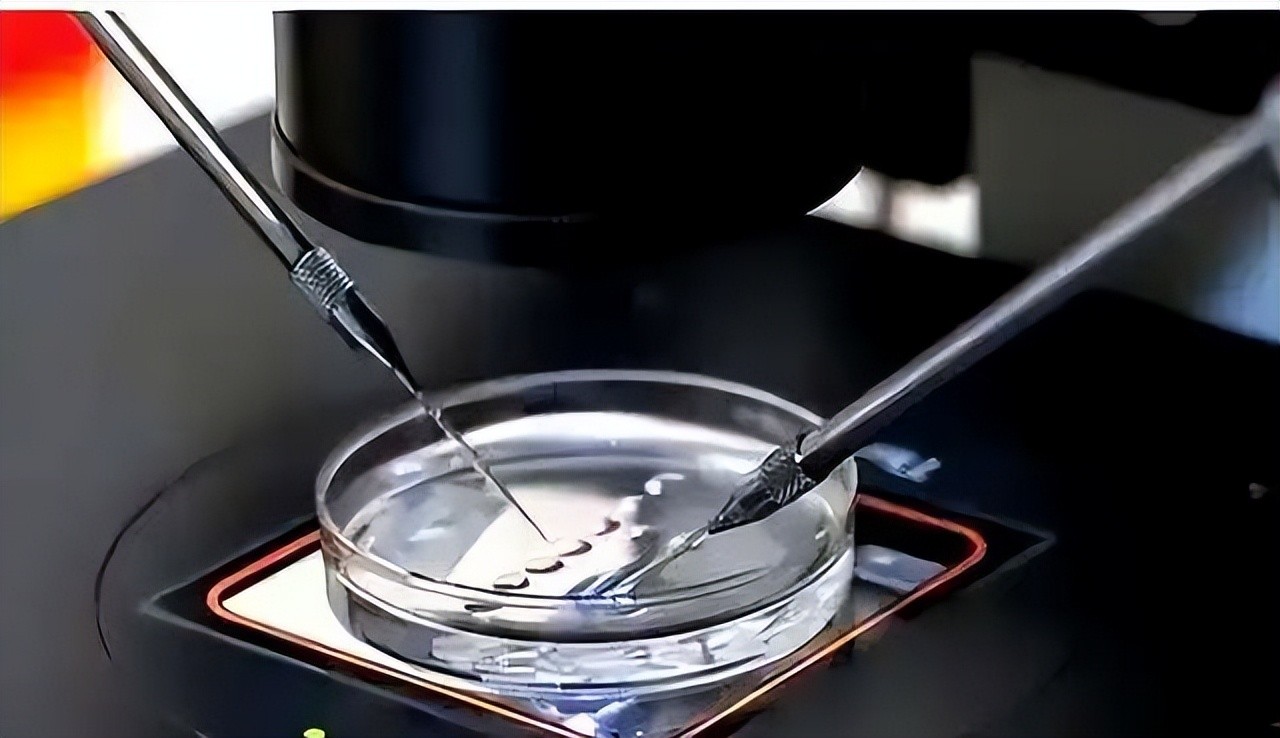

捐精狂魔乔纳森:和同伙混合精子捐献,害苦全球3000个不孕家庭
捐精狂魔乔纳森:和同伙混合精子捐献,害苦全球3000个不孕家庭
声明:本文内容均是根据权威资料,结合个人观点撰写的原创内容,文末已标注文献来源以及截图,请知悉。
在如今的科技时代中,不少的科学技术在不断的解决着家庭中的生育问题,这些技术为家庭带来了希望与暖意。
这原本对不少家庭来说是件好事,但是当这些技术被人开始肆意妄为的滥用,当这些技术开始成为某些人报复的工具,那么将极有可能会在社会上引发严重的伦理危机。

在2023年的3月底的时候,在荷兰便发生了一起因为男子疯狂捐精子,而导致受其精子出生的孩子最少的预估也已经高达500多名,危害的家庭将近高达3000个。
乔纳森的捐精的行为原本从开始的善心举动,变成了大家现如今的噩梦,他们害怕更多乔纳森的孩子出世,他们担忧自己的孩子无法面对伦理世界。
不得不说他们的担忧是不无道理的,但是让人感到十分好奇的是乔纳森为何会产生捐精的想法呢?他又是怎么和大家联系上的?又是为何产生如此疯狂的捐精想法呢?这究竟是怎么一回事?

乔纳森的捐精
要知道在荷兰亦或是比利时还是澳大利亚,每个国家之中都有些女同想要拥有孩子,每个国家之中也有不少无法自然受孕的夫妻,更是有些独居女性也想要拥有自己的孩子。
那么他们想要孩子的方法就可以通过去精子银行之中去选精子然后受孕,要么就是在私下购买精子来受孕。

由于国外的精子库技术十分的成熟,因此也有不少的人选择开设私人的精子网站来供大家选择。
大家可以选择的有许多,但是毋庸置疑的是每个母亲都希望自己的孩子拥有的是良好的基因,因此大家都开始在镜子银行和私人精子网站之中寻找让自己满意的匹配者。
在寻找的时候,有不少的人都关注到了乔纳森,因为首先乔纳森的外貌十分出众,不仅有深邃的眼睛,更是有一头让人喜爱的金发。

许多的女性看到乔纳森的金发后,都开始不由自主的幻想,如果要是自己与乔纳森的基因所结合起来,生出来的孩子继承了乔纳森的金发,该是有多么的美丽。
因此通过乔纳森的外貌,不少人都产生了更多想要了解乔纳森的想法,因此大家都选择从社交平台上了解乔纳森。
于是大家纷纷都在油管上找到了乔纳森的账号,在账号之中,她们都发现乔纳森本人是十分自信开朗的男性。
常常去各个地方旅游生活,可以看出乔纳森是位特别向往自由的人,而除此之外,通过乔纳森演奏吉他,也可以看出来乔纳森在音乐上有一定的天赋。
经过乔纳森的油管账号,不少的女性对乔纳森十分满意,她们都不约而同的决定了,要将乔纳森约出来商谈取精子的事宜。

在现实生活中,乔纳森与各位女性都见面,他十分的有礼貌,表明自己最多会提供给五位女性,来确保社会的稳定。
乔纳森的说法让大家都庆幸万分,庆幸自己是五个之一,在商讨决定之后,便开始了人工授精,在过程中乔纳森尽量会满足各个家庭的不同需求,也会解决她们在取精子回家遇到的困难。

经过两三次的尝试后,大家都最终迎来了好消息,怀上了孩子,经过了长时间的等待,大家在生下孩子后,都对孩子开始倾注自己的爱意。
而随着孩子们的长大,一位在幼儿园工作的女性也在生下孩子后回到了园内工作,在工作的时候,她意外得知自己的同事也是在私人精子库中挑选授精怀孕的。

除此之外,更是了解到该同事的家里有各个亲属也是同样的方式怀孕的,起初她觉得这很正常,但是随着了解,她发现同事口中的人和乔纳森很像。
而与此同时,不止是她,还有不少的女性发现自己的孩子和某些孩子长得十分相似,看上去就和一个模子里刻出来的一样。

这些发现让人感到恐怖不已,最终通过新闻的报道,大家开始纷纷得知真相,原来有位捐精者,竟然将精子捐到各大精子银行和诊所之中,供人挑选,甚至就连私人精子库也不放过。
现如今该名男子已经至少有500名孩子,这件事情一经报道,立刻让人感觉到毛骨悚然,不少人更是发觉,新闻中说的男子极有可能就是乔纳森。
这让不少人开始担忧起了自己的孩子,因为按照新闻所说,乔纳森的孩子不知道究竟有多少,如果乔纳森的孩子与自己的孩子认识或者产生情愫,那岂不是违背了伦理?

一想到会引起伦理失常的后果,与乔纳森合作的女性无不好奇究竟乔纳森为何要选择这样做?他为什么要将社会扰乱?
那么乔纳森是为何会开始的?又是在什么样的机缘之下决定要捐献多个?

乔纳森捐精子的初衷
据了解,乔纳森产生想要捐出精子的想法,是在他上大学的时候,他上大学的时候,就听说了精子银行的事情,刚开始的乔纳森觉得这是件好事。
是帮助不同家庭让她们更加完整的好事,但是乔纳森十分不喜精子银行通过交易来获取精子的方式,因此他便产生了想法。

于是他便将自己的精子以不同的名义放入到各大精子银行之中,还在私人网站上将自己的精子和信息也放了上去。
乔纳森在做这些的路上,遇到了和他有不谋而合想法的里昂,两人于是便开始了这场扰乱社会秩序的操作。

事情真相大白
只是这场扰乱秩序操作也终于有一天会迎来引起大家注意的一天,一天,在正规医院上班的一名医生收到了一封举报信。
信中的内容是说现如今在该地区已经有超过100名孩子来自于同一个父亲,现如今的数量还在不停的上升。

在医生得知后,很快便开始调查事情,在经过调查后,他最终确定了此人就是乔纳森,而在医生查清事件的同时,乔纳森也被人举报上了法庭。
奈何最终没有明确的法律限制乔纳森的行为,因此法院最终只能想出让乔纳森罚款的想法来约束。
参考资料:
千子之父:捐精狂奇案丨纪录片
“海王式”捐精成为550名孩子的生父 荷兰一男子被判禁止捐精,再捐每次罚款10万欧丨红星新闻
男子疯狂捐精,现在至少是550个孩子的爸爸!他还自称是个音乐家……丨每日经济新闻
外媒:荷兰男子捐精时违规操作,成为至少550名孩子“父亲”丨环球网




-

- 从奇异事件调查到罗布泊双鱼玉佩
-
2025-12-11 13:41:51
-

- 世界杯史话,因乌龙球被杀身亡,埃斯科巴成哥伦比亚悲剧之殇
-
2025-12-11 13:39:36
-

- 二十六史精选故事422、陈玄奘西天取经
-
2025-12-11 13:37:20
-

- 国防服役纪念章发放标准太高了,估计有一半当过兵的人都领不到
-
2025-12-11 02:28:19
-

- 告别老气!这些短发发型让50-60岁女士重焕青春
-
2025-12-11 02:26:03
-
- 向太年轻时的照片曝光,和当红女星同框都不输难怪向华强一见钟情
-
2025-12-11 02:23:48
-

- 宋冬野吸毒后演出被取消喊冤枉;你同意他复出吗
-
2025-12-11 02:21:32
-

- 日韩女星知多少——Jennie
-
2025-12-11 02:19:16
-

- 农村生意:6个不起眼的项目,年赚20万不是梦!
-
2025-12-11 02:17:00
-
- 【榜单】重庆这些热门景区在抖音刷屏了,前三名你都去过吗?
-
2025-12-11 02:14:45
-

- 有这些信号,说明你头脑非常灵活
-
2025-12-11 02:12:29
-

- 五本破镜重圆的校园文:男主深情忠犬,一直等待她,心底温柔是你
-
2025-12-11 02:10:13
-

- 热搜!女子在公司微信群看到自己被裁员,法院这样判
-
2025-12-11 02:07:57
-

- 麦当劳(中国)公司更名,它现在的名字叫“金拱门”|关注
-
2025-12-11 02:05:42
-

- 科员到正处,15年够不够,我们一起来算算
-
2025-12-11 02:03:26
-

- 福建省第一届职业技能大赛举行颁奖典礼 厦门集美职校台生斩获一枚银牌
-
2025-12-11 02:01:10
-

- 浙江湖州五大美食,没吃过白去了!
-
2025-12-11 01:58:55
-

- 映客大主播手撕八卦号,称早就想起诉她了,对方:过气想火
-
2025-12-11 01:56:39
-

- 河蚌营养美味,为什么却没人吃河蚌?吃河蚌的危害很大吗?
-
2025-12-11 01:54:23
-

- 爱福窝已经被并购完成
-
2025-12-11 01:52:07



 8本超好看的高干文:京圈大佬对女主情有独钟的小说,好有张力!
8本超好看的高干文:京圈大佬对女主情有独钟的小说,好有张力! 莉萨·安(Lisa Ann)
莉萨·安(Lisa Ann)